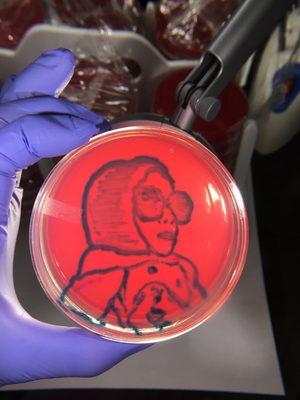

I had an emergency dental appointment for my son, the cap for his tooth fell off and we were seen within an hour after I called! Stephanie and Yolanda were amazing as well! My child was very...
Li'l Teeth Dentistry
(16)
Photos
Also at this address
Find related places
Reviews
I moved my kids to this dentist after their prior dentist kept rescheduling their appointment and changing the times on us like our schedule should revolve around what was convenient for them....
They cancelled all of their existing appointments in their computer system due to Covid-19 but neglected to contact those patients personally to reschedule. They reopened in May, yet nobody from...
They say they will send an email to have paperwork done prior to appointment, Do they call to confirm or reschedule appointment..... NO!! Before covid we came to this location a few times...
Not only did they take out the wrong tooth, the front desk lady hit on my husband while my children were right by his side , charged me $325 for a cleaning when I was told it would be only $80 ,...